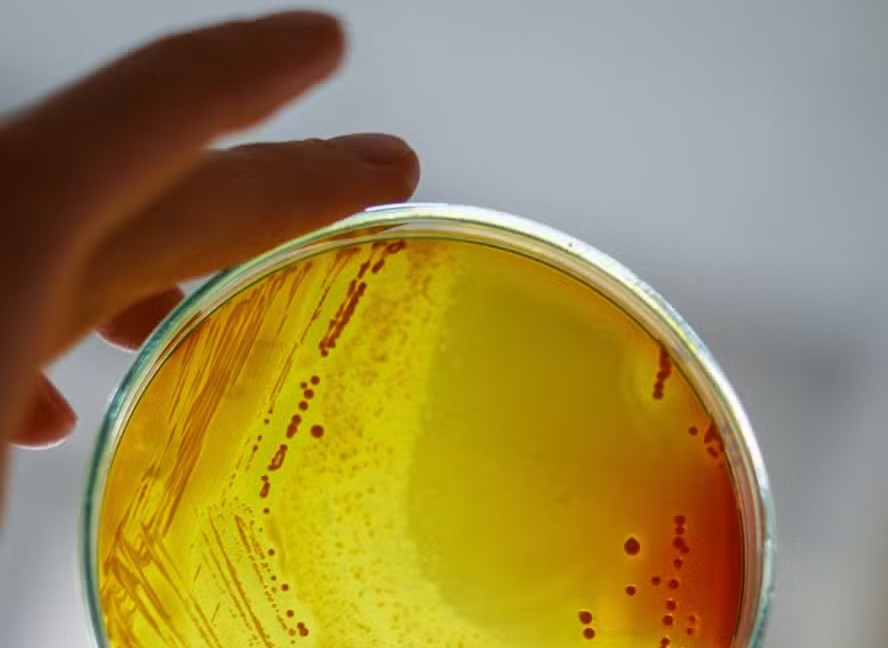
Cultura de laboratório da bactéria Staphylococcus aureus

Menos de 0,5% dos pacientes com bactérias resistentes no Brasil têm acesso ao tratamento adequado
Novo estudo aponta que percentual é inferior até mesmo ao de outros países de média e baixa renda, como Índia e Paquistão
Menos de 0,5% dos pacientes com bactérias multirresistentes no Brasil têm acesso ao tratamento com antibióticos adequados. O percentual é baixo até mesmo entre os países de média e baixa renda, cuja proporção foi de em média 6,9%. É o que mostra um novo estudo conduzido pela Parceria Global de Pesquisa e Desenvolvimento de Antibióticos (GARDP, na sigla em inglês), publicado na revista científica The Lancet Infectious Diseases.
A resistência antimicrobiana (RAM) é um fenômeno que acontece quando microrganismos, como fungos e bactérias, deixam de ser suscetíveis aos medicamentos existentes. Com isso, o risco de um desfecho mais grave, como um óbito, aumenta. A RAM é considerada uma das 10 principais ameaças de saúde pública pela Organização Mundial da Saúde (OMS).
Anualmente, uma análise publicada no periódico The Lancet mostrou que essas superbactérias foram responsáveis diretamente pela morte de 1,27 milhões em 2019, número maior do que o de óbitos ligados a doenças como malária e Aids. Indiretamente, a RAM foi associada a 4,95 milhões de vidas perdidas.
Leia também
• Conheça o truque da luz solar que pode reduzir a fadiga pela manhã, segundo estudo
• Novo esporte da moda pode aumentar risco de doenças pulmonares, diz novo estudo
• Novo estudo alerta sobre ligação de plásticos e doenças cardíacas; veja o que você precisa saber
Nas próximas décadas, o problema deve piorar. O número de vítimas fatais diretas pode chegar a 1,9 milhão anualmente até 2050, um crescimento de 67% em relação a 2021. De acordo com os pesquisadores, ao todo, entre 2025 e 2050, mais de 39 milhões de pessoas no mundo podem morrer devido à RAM.
Neste contexto, um dos focos no debate tem sido o uso indevido e excessivo de antibióticos, por vezes devido à automedicação. A prática é considerada uma das causas para que as bactérias evoluam e desenvolvam a capacidade de sobreviver aos medicamentos.
No entanto, Jennifer Cohn, diretora de Acesso Global da GARDP e autora sênior do novo estudo, afirma que, no caso a infecção com as versões resistentes das bactérias, “a dura realidade é que muitas pessoas em países de baixa e média renda não têm acesso aos antibióticos de que precisam”.
Logo, o trabalho mostra que, embora o uso inadequado de antibióticos alimente o problema da RAM, aqueles que já sofrem com os microrganismos resistentes não conseguem acessar o tratamento adequado e morrem mais pela infecção. Os pesquisadores da GARDP defendem que esse também precisa ser um foco do combate à RAM.
No estudo, eles analisaram dados de oito países de média e baixa renda: Bangladesh, Brasil, Egito, Índia, Quênia, México, Paquistão e África do Sul. Os cientistas observaram, segundo dados de 2019, cerca de 1,5 milhão de infecções de um tipo específico de bactéria resistente, as gram-negativas resistentes a carbapenêmicos (uma classe de antibióticos).
Dentre eles, porém, somente 103,6 mil receberam o tratamento adequado (6.9%). Esse percentual foi maior no México e no Egito, onde chegou a 14,9%, e menor no Brasil e no Quênia, onde foi de, respectivamente, 0,36% e 0,25%. No Brasil, foram cerca de 101 mil casos, e apenas 363 com acesso aos remédios necessários. Além disso, o trabalho concluiu que 478,8 mil mortes ocorreram nos países analisados naquele ano, 32,3 mil entre os brasileiros.
Para a professora de Infectologia da Faculdade de Medicina da Universidade Federal do Rio de Janeiro (UFRJ), que pesquisa infecções em pacientes hospitalizados, o estudo dá uma nova dimensão ao problema da RAM no Brasil:
— Esse dado é inédito, a resistência microbiana é uma questão ainda muito negligenciada. Isso é muito importante, porque estamos falando de pessoas que provavelmente não estão recebendo o diagnóstico certo e, portanto, não têm acesso ao tratamento adequado. É fundamental entendermos por que isso está acontecendo e buscar responder às perguntas que o artigo levanta.
Ela explica que há algumas lacunas que precisam ser preenchidas, como o número de pessoas diagnosticadas adequadamente com a infecção resistente aos antibióticos convencionais e o porquê do tratamento não chegar até elas. O que é uma desafio devido à estrutura necessária e à diversidade dos microrganismos, pontua:
— Esses microrganismos vão se modificando em cada hospital e é preciso que as unidades tenham mecanismos de diagnóstico de ponta, que são caros, para identificá-los. E que consigam fazer esse diagnóstico rapidamente, a tempo de beneficiar o paciente.
Além disso, a especialista explica que outro desafio no combate à RAM é ter novos fármacos capazes de atacar as bactérias resistentes. Como os microrganismos passaram a se disseminar muito rapidamente, principalmente em unidades hospitalares, e com mecanismos de resistência diferentes, ficou mais difícil para as farmacêuticas desenvolverem moléculas eficazes a tempo, afirma:
— E como são remédios usados por pouco tempo, o retorno financeiro para as indústrias é menor, diferente do que acontece para medicamentos de doenças crônicas, como diabetes, obesidade, por exemplo. E enquanto pensamos em novos antimicrobianos, as bactérias já desenvolveram novos mecanismos de resistência, porque para elas é uma questão de sobrevivência.